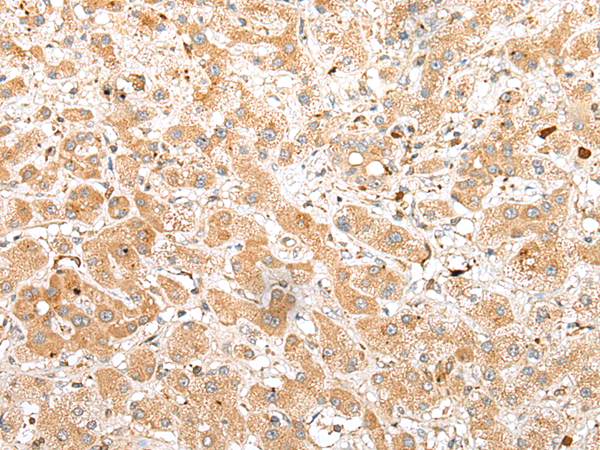

|
Background: |
The protein encoded by this gene is a cis-trans peptidyl-prolyl isomerase that may function in immunoregulation and basic cellular processes involving protein folding and trafficking. This gene is located in a chromosomal region that is deleted in Williams-Beuren syndrome. Defects in this gene may cause male infertility. There are multiple pseudogenes for this gene located nearby on chromosome 7. Alternative splicing results in multiple transcript variants. |
|
Applications: |
ELISA, IHC |
|
Name of antibody: |
FKBP6 |
|
Immunogen: |
Full length fusion protein |
|
Full name: |
FK506 binding protein 6, 36kDa |
|
Synonyms: |
FKBP36 |
|
SwissProt: |
O75344 |
|
ELISA Recommended dilution: |
5000-10000 |
|
IHC positive control: |
Human liver cancer and Human esophagus cancer |
|
IHC Recommend dilution: |
25-100 |
購物車
幫助
021-54845833/15800441009
